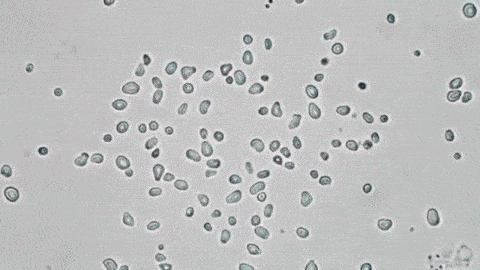
Partículas de polen en el microscopio

En 1827, el botánico escocés Robert Brown observaba al microscopio granos de polen flotando en agua cuando notó algo extraño: las pequeñas partículas se movían de manera errática sin ninguna razón aparente. Para asegurarse de que no era porque estaban vivas, repitió el experimento con polvo y ceniza, y vio que también se movían solas. No tenía ninguna explicación para esto, pero el fenómeno quedó registrado como "movimiento browniano".
Desde la Antigua Grecia, en el siglo V a.C., filósofos como Demócrito decían que toda la materia estaba formada por pequeñas partículas llamadas átomos. Sin embargo, durante la Edad Media, la Iglesia y muchos científicos preferían pensar que la materia era continua, sin divisiones invisibles. Incluso en el siglo XIX, muchos científicos aún dudaban de la existencia real de los átomos porque nadie los había visto directamente.
Aunque algunos químicos, como Dalton, usaban la idea de los átomos para explicar reacciones químicas (que se juntan para formar moleculas y así las sustancias), otros creían que los átomos solo eran una herramienta matemática, no algo real. El movimiento browniano era un misterio sin resolver hasta que Albert Einstein propuso una explicación en 1905.
Einstein propuso que las partículas de polen no se movían por sí solas, sino porque estaban siendo golpeadas por partículas invisibles: las moléculas de agua en constante movimiento. Según su idea, las moléculas de agua chocaban con las partículas de polen y las empujaban en distintas direcciones, haciendo que se movieran de forma aleatoria.
Aunque los átomos y las moléculas eran demasiado pequeños para verlos, sus efectos podían observarse a través del movimiento browniano. Einstein incluso desarrolló ecuaciones matemáticas para predecir cómo debían moverse estas partículas si la teoría de los átomos era correcta.
El físico Jean Perrin, en 1908, decidió probar la teoría de Einstein. Hizo experimentos midiendo el movimiento browniano con gran precisión y encontró que coincidía exactamente con las predicciones matemáticas de Einstein. Este fue el punto de quiebre: la comunidad científica finalmente aceptó que los átomos existían de verdad y no solo eran una idea teórica.
El movimiento browniano sigue siendo clave en la ciencia. Se usa en biología para entender cómo se mueven las moléculas dentro de las células, en nanotecnología para manipular partículas diminutas y en física para estudiar sistemas complejos.
Lo que comenzó como un enigma para Robert Brown terminó siendo una de las pruebas más importantes de que la materia está formada por átomos. Gracias a la explicación de Einstein y la confirmación experimental de Perrin, se abrió una nueva era en la física y la química, permitiendo muchos avances científicos y tecnológicos.